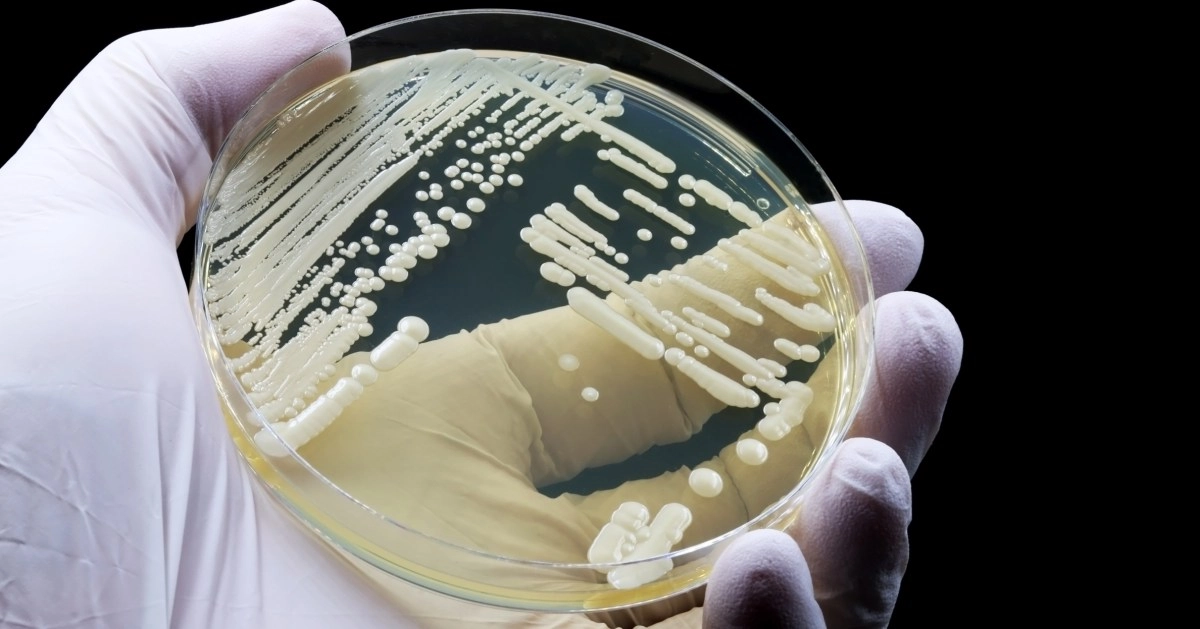
Hongo mortal Candida auris se est propagando por todo Estados Unidos

Deadly Fungus Candida auris Is Spreading Across the United States
The dense cell wall structure of Candida auris contributes to its remarkable drug resistance
Candida auris, a fungus first identified in Japan in 2009, has proliferated in the United States, with at least 7,000 infections reported in 27 states by 2025, according to the Centers for Disease Control and Prevention (CDC). This increase has resulted in a wider recognition of its virulence and resistance to conventional treatments. A recent study from the Hackensack Meridian Center for Discovery and Innovation, published in Microbiology and Molecular Biology Reviews, has revealed that the dense cell wall structure of Candida auris contributes to its remarkable drug resistance. This fungus has evolved to evade host interactions, making it a significant threat, especially to people with compromised immune systems. Diagnosis and Treatment Laboratory tests to identify Candida auris have proven complicated, often leading to erroneous results due to confusion with other yeasts. Although four classes of antifungal medications are available, their effectiveness varies. Currently, three new drugs are in clinical trials, raising hopes for better treatment options in the future. Prevention Strategies: Researchers emphasize the need to develop new antifungal agents and improve diagnostic tests. “Taken together, these data underscore the need to develop new antifungal agents with broad-spectrum activity against human pathogenic fungi, improve diagnostic tests, and develop complementary immune-based modalities and vaccines for the treatment of high-risk patients,” the researchers said in a joint statement reported by Newsweek. Furthermore, the importance of creating more effective surveillance mechanisms, especially in resource-limited countries, to manage and improve outcomes for patients affected by opportunistic fungal infections is highlighted.
Symptoms of Candida auris Infection
The most common symptoms of a Candida auris infection include high fever and chills that do not improve with antibiotics.
General Symptoms. Candida auris causes serious infections, especially in the bloodstream, with signs such as fatigue, dizziness, increased heart rate, and vomiting. These symptoms are similar to other fungal or bacterial infections, which complicates its identification in patients who are already hospitalized.
Symptoms by Location. Depending on the affected site, wound, ear, or urinary tract infections may occur, with persistent fever and low blood pressure in severe cases. In immunocompromised patients, the infection spreads rapidly without noticeable specific symptoms at first.
Risk Factors
The main risk factors for contracting Candida auris infections are related to hospital settings and conditions of medical vulnerability.
Hospital Factors.
Prolonged hospitalizations, stays in nursing homes, and contact with contaminated surfaces increase the risk of colonization and infection by Candida auris, as this fungus persists in the environment and is easily transmitted. The presence of invasive devices such as central venous catheters, mechanical ventilation tubes, and urinary catheters facilitates the entry of the pathogen. Medical conditions: Patients with immunosuppression, multiple comorbidities (such as diabetes or cancer), recent surgeries, or prolonged use of broad-spectrum antibiotics and antifungals are more susceptible. Previous cutaneous colonization, detected in the armpits, groin, or rectum, increases the likelihood of invasive infection in these groups. You may also be interested in:
Risk Factors
The main risk factors for contracting Candida auris infections are related to hospital settings and underlying medical conditions.
Hospital Factors. Prolonged hospital stays, residences in nursing homes, and contact with contaminated surfaces increase the risk of colonization and infection by Candida auris, as this fungus persists in the environment and is easily transmitted. The presence of invasive devices such as central venous catheters, mechanical ventilation tubes, and urinary catheters facilitates the entry of the pathogen.
Medical Conditions. Patients with immunosuppression, multiple comorbidities (such as diabetes or cancer), recent surgeries, or prolonged use of broad-spectrum antibiotics and antifungals are more susceptible. Previous skin colonization, detected in the armpits, groin, or rectum, increases the likelihood of invasive infection in these groups.
You may also be interested in:


